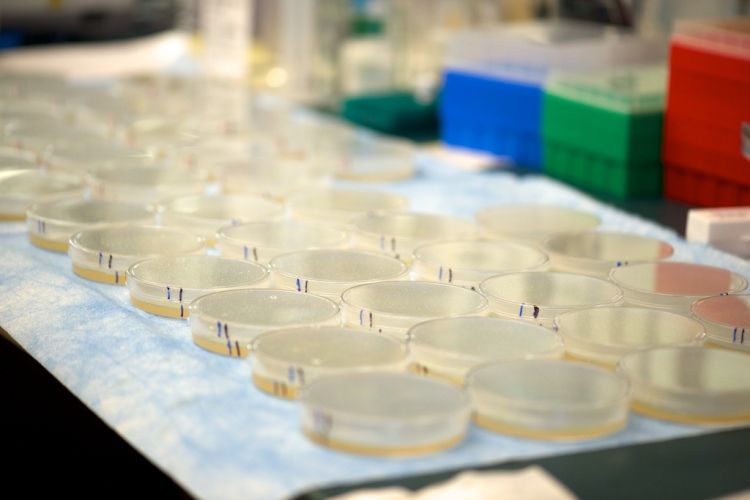
Four of 13 UW-Madison Microbiome Initiative Projects Involve Department of Medicine Members

Four of 13 UW-Madison microbiome initiative projects involve Department of Medicine members
In recent years, advances in DNA sequencing technology have allowed scientists to glimpse the brilliant diversity of the microbial world in and on the human body—but our understanding of how the microbiome affects health is still in its infancy.
To galvanize the UW-Madison research community’s focus on microbiome research, the Office of the Vice Chancellor for Research and Graduate Education has launched the 2017 UW-Madison Microbiome Initiative, which provides seed funding for eight research projects, four infrastructure projects and one research community enhancement award.
Each grant is funded for two years, with research and infrastructure grants being awarded up to $250,000 and research community enhancements up to $10,000. The Wisconsin Alumni Research Foundation (WARF) and the Graduate School also provided support for the initiative.
Four of the 13 projects selected for funding involve Department of Medicine members. They are:
- Contributions of Gut Microbes to Alzheimer’s Disease, led by principal investigator Barbara Bendlin, PhD, associate professor, Geriatrics and Gerontology and co-principal investigator Federico Rey, PhD, assistant professor, Department of Bacteriology. Other department collaborators include Luigi Puglielli, MD, PhD, professor, and Sterling Johnson, PhD, professor, both of Geriatrics and Gerontology. This project will test whether Alzheimer’s disease is caused, or at least influenced, by the gut microbiome.
- Examining the Potential of the Microbiome in Children to Reduce Antibiotic Resistance: the EPIC Study led by Nasia Safdar, MD, PhD, associate professor, Infectious Disease and co-principal investigators Garret Suen, PhD, associate professor, Department of Bacteriology and Ellen Wald, MD, professor and chair, Department of Pediatrics. Collaborators include Daniel Shirley, MD, MS, assistant professor (CHS), Infectious Disease. The "Examining the Potential of the Microbiome in Children to Reduce Antibiotic Resistance" (EPIC) study will examine the impact of daycare on a child’s microbiome and risk of infection with drug-resistant pathogens.
- Establishment of a Population-based Microbiome Research Core in the Survey of the Health of Wisconsin led by Ajay Sethi, PhD, MHS, associate professor, Department of Population Health Sciences and nine co-investigators including Dr. Nasia Safdar. This project will create the Population-based Microbiome Research Core (PMRC) in the Survey of Health of Wisconsin (SHOW).
- A Germ-free Mouse Facility for the UW–Madison Community led by Dr. Federico Rey and co-principal investigator Richard Halberg, PhD, associate professor, Gastroenterology and Hepatology. Collaborators include Dudley Lamming, PhD, assistant professor, Endocrinology, Diabetes and Metabolism. This project funds creation of a germ-free facility that will provide services for the whole UW-Madison research community.